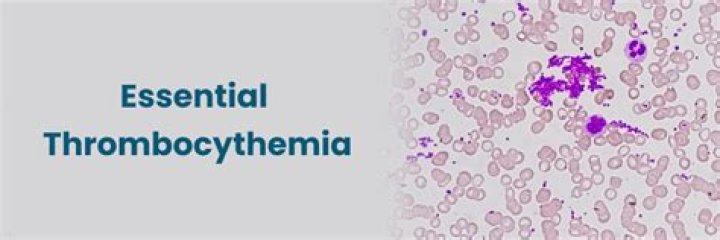

What is a dormer door

Ava Robinson
Updated on April 21, 2026
Dormer doors open up a whole new way to access hidden storage space in your home. These attic access doors serve a highly functional purpose without detracting from the aesthetics of your home. Solid core, pre-hung, weather striped doors make attic access a breeze.
Why is it called a dormer?
The term derives from the Latin dormitorium, “sleeping room.” Dormers are set either on the face of the wall or high upon the roof, and their roofs may be gabled, hipped, flat, or with one slope. …
How does a dormer work?
Located on the sloped side of a roof, a dormer window brings natural light into an attic, loft, or any room with a vaulted ceiling. This type of window sits vertically in a framed structure that juts outward from the pitch of the main roof and features a little roof of its own above the window.
What is the benefit of a dormer?
Source of light – Having dormer windows installed can help bring natural light into a space. This can help improve the overall environment of the area. Ventilation – Additional windows mean additional airflow – aerating a space can also help make the area more livable.Can I put a dormer on the front of my house?
Dormers are usually added to the rear, but subject to planning permission, they can be added to the side or front of your property.
Are dormers expensive?
It typically costs between $2,500 to $20,000 for professional dormer installation, or about $115 per square foot. There are several options for dormers, including shed, flat, gable and hip. Smaller projects, like adding a window dormer, cost about $4,000. Larger remodels like adding a bathroom dormer run about $24,000.
What is the difference between a dormer and a mansard?
The only difference with a mansard is that the slope across the face of the mansard will make the construction look softer from the outside. It will, however, sacrifice some head height compared to a dormer that is built vertical off of the back wall.
Do dormer windows add space?
On the inside, what may be dark, attic space can become habitable with a dormer window. An additional bathroom can be enlarged by a dormer tucked into a large bedroom. Besides additional space for a home, natural light and ventilation can make interiors more inviting and healthier.Can you add dormers to an existing roof?
If you’re looking to install a new dormer to your existing roof, it typically costs between $2,500 to $20,000, or $115 per square foot, depending on the size of the dormer you want to install. … The typical cost to add a dormer is $2,500 to $20,000, with an average cost of $12,000.
What are the advantages and disadvantages of a gable with dormer roof?Advantages: These are easy to design, and they keep costs down, while also providing a slope for water to drain off. Disadvantages: High winds can be a problem for gable roofs if they’re not well constructed, especially if there is too much overhang, in which case, the entire roof could be torn free.
Article first time published onHow long do dormer roofs last?
2 Answers from MyBuilder Roofers Fibreglass – 25 years plus. All of course dependent on workmanship and degree of weathering the roof gets (shaded roofs may last long).
Can any house have a dormer?
A dormer loft conversion is an extension that protrudes from the slope of the roof. Dormers, in particular flat-roof dormers, are the most popular type of conversion. They’re suitable for pretty much any home with a sloping roof.
Do dormer windows need gutters?
Dormer windows with pitched roofs usually have valleys behind them, gutters to capture the water from the dormer roof, and side abutments. … There are gutters each side of the dormer roof slopes. Rainwater from the main roof directly above the dormers is draining into the valleys behind the dormers.
What's the cheapest loft conversion?
Roof Light Conversion A roof light loft conversion is the easiest and most affordable type of loft conversion. These types of loft conversion are quite basic. They only consist of reinforcing the attic floor and adding windows.
Can my Neighbour stop my permitted development?
Can neighbours stop permitted development? Property under permitted development does not require planning permission, meaning the public, and neighbours, typically cannot object to the development.
Can Neighbours stop loft conversion?
You do not normally need permission from your neighbours for your loft conversion, nor Planning Permission from your council (as loft conversions are usually counted as “Permitted Development”, but you may need to have a Party Wall Agreement if the project is in a terraced or semi-detached property.
What is the purpose of a dormer on a house?
Dormers are commonly used to increase the usable space in a loft and to create window openings in a roof plane. A dormer is often one of the primary elements of a loft conversion. As a prominent element of many buildings, different types of dormer have evolved to complement different styles of architecture.
Do you need planning permission for a dormer?
Dormer windows, like dormer conversions, are usually classed as permitted development the same as roof windows and skylights. So, you won’t need planning permission for dormer windows unless they exceed certain measurements or if you live in a listed building or conservation area.
What is the difference between a loft conversion and a dormer?
A rear dormer conversion is the most typical Loft Conversion carried out. … A rear dormer conversion allows you to keep a sloped roof at the front where Velux windows can be fitted to allow natural light to pour in. The rear dormer is an ideal way to create more head and floor space at the back of the attic.
Can you put a bathroom in a dormer?
Bathroom dormer additions can be an effective way to gain some extra square feet and headroom to put in a small bathroom in an otherwise tiny area. However, bathroom dormer additions can be complicated, and thus expensive to do. Below are some important topics to think about when considering a bathroom dormer addition.
Do dormers leak?
The leak is usually caused by flashing around the dormer area being improperly installed or nonexistent. The best way to repair a roof leak around a dormer is to use step flashing. … Step flashing is a structural metallic barrier between the walls of the dormer and the roof.
How much does it cost to raise your roof?
Cost of Raising a Roof on a House. It typically costs between $15,000 and $125,000 and up to raise a roof on a house. Removing, replacing or moving plumbing and electrical work can increase price. Nationally, the cost to replace or install a roof is about $8,000.
How long does it take to build a dormer?
Dormer conversions – 5 weeks on average. Hip-to-gable conversions – 6 weeks on average. Mansard conversions or full roof replacements – 7-8 weeks on average.
How wide should a dormer be?
Experts at This Old House recommend that, in general, when deciding on size, you allow the dormer to be a design feature that doesn’t overpower your home. The windows should be smaller than the other windows already on your home, and dormers should not occupy more than half the entire width or depth of your roof.
What is a house with dormers called?
Colonial. Historically this style refers to a rather broad time period architecturally, a Colonial house is regarded as a one- or two-story, rectangular, eaves-front symmetrical building with a central entrance. In a Georgian Plan, this is sometimes referred to as “five-over-four and a door,” and may have roof dormers.
How much value does Dormer add?
In fact, research carried out by Nationwide Building Society states that adding a bathroom or bedroom to your home through a loft conversion can add over 20% to a property’s value; that’s a lot of extra money to cash in on when you come to sell up in the future.
Which is cheaper hip or gable roof?
Hipped roofs are more expensive to frame than gable roofs. Get cost estimates on roofing from local contractors below. Hip roofs are more expensive to build than gable roof because it is a more complex design that requires more building materials including a complex system of trusses or rafters.
What roof is better hip or gable?
Hip roofs are typically more stable than gable roofs because they consist of four slopes rather than two. Since they are a bit sturdier, these roofs are a better choice for areas that experience high wind.
What roof style is best?
A hipped roof is the most stable roof style because weight is evenly distributed around its base. Additionally, its shape is more resilient against high winds and heavy rains, making it a great option for people that live in areas where severe storms are common.
Are dormer roofs flat?
Flat roof dormer. This type of dormer comes with a single flat plane roof which is more or less horizontal. Although, many flat roofs are fitted with a slight inclination which lets rainwater run off more effectively.
Can you have two dormers?
Can I have two Dormers? Sometimes it’s possible to have two dormers built as part of a loft conversion, which will really maximise the space in your loft. This can work particularly well if you have one dormer to the front or rear of the property, and one to the side.